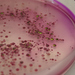
image.title

-
Laboer Wasser- und Abwassermirkobiologie
© Hochschule Offenburg
-
Laboer Wasser- und Abwassermirkobiologie
© Hochschule Offenburg
-
Laboer Wasser- und Abwassermirkobiologie
© Hochschule Offenburg
-
Coli Platten
© Almut Henninger HS Offenburg